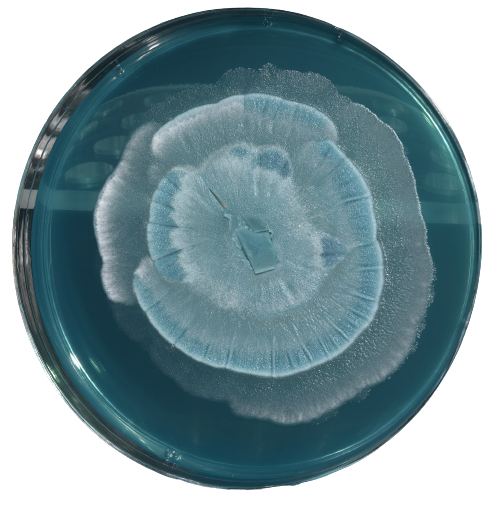

BETTER INGREDIENTS
WHAT'S IN HAVEN
Our essential ingredients

A2 Protein Cow Whole Milk
Our Cow infant nutrition range is made from A2 protein milk sourced from hand-selected New Zealand farms where cows grass on grass pastures year-round.
A2 protein milk may be a beneficial option for some babies, particularly those who experience digestive discomfort with regular cow's milk or who have a family history of lactose intolerance or dairy sensitivity.
Here are some of the key benefits of A2 protein milk for babies:
Easier digestion: A2 protein milk may be easier for babies to digest than regular cow's milk. This is because A1 protein can be broken down into a peptide called beta-casomorphin-7 (BCM-7), which has been linked to digestive discomfort in some infants. By contrast, A2 protein milk doesn't contain A1 protein, so it may be easier on an infant's digestive system.
Nutritional benefits: A2 protein milk contains a range of important nutrients that are essential for infant growth and development. For example, it is a good source of protein, which is important for building and repairing tissues in the body. It also contains calcium, which is essential for strong bones and teeth, as well as vitamin A, which plays a role in maintaining healthy eyesight and a strong immune system.
May reduce colic: Colic is a common condition in infants that causes excessive crying and fussiness. While the causes of colic are not well understood, some research suggests that it may be related to an infant's ability to digest lactose and protein. Some parents have reported that switching their infant to A2 protein milk has helped reduce symptoms of colic, although more research is needed to confirm this effect.
May be a suitable option for babies with dairy sensitivities: Some infants may be sensitive to cow's milk protein, which can cause symptoms such as vomiting, diarrhea, and skin rashes. A2 protein milk may be a suitable alternative for these infants, as it doesn't contain A1 protein, which some infants may be particularly sensitive to.
May be a suitable option for babies with a family history of dairy intolerance: If there is a family history of lactose intolerance or dairy sensitivity, parents may wish to consider offering A2 protein milk to their infants. While it still contains lactose, the absence of A1 protein may make it easier for some infants to

Goat Whole Milk
Our Goat range is made from fresh New Zealand whole goat milk and is sourced from select farms in the North Island of New Zealand.
Goat milk is naturally A2 protein milk and is a gentle alternative to cow’s milk and a great option for infants who have trouble digesting cow's milk.
Here are some of the key benefits of goat milk for babies:
Easier digestion: Goat milk contains smaller fat globules and a different protein structure than cow's milk, which may make it easier for babies to digest. Some parents have reported that switching to goat milk has helped reduce symptoms of colic, reflux, and digestive discomfort in their babies.
Nutritional benefits: Goat milk is a good source of protein, calcium, and other important nutrients that are essential for infant growth and development. It is also rich in medium-chain fatty acids, which are easily absorbed and provide a source of energy for the body.
May reduce allergies: Some babies may be allergic to the proteins found in cow's milk, which can cause symptoms such as rashes, wheezing, and digestive upset. Goat milk contains different proteins than cow's milk, which may make it a better option for babies with cow's milk allergy. However, it's important to note that goat milk can still cause an allergic reaction in some babies, so it's important to introduce it gradually and monitor for any signs of allergy.
May support immune function: Goat milk contains several components, including oligosaccharides and immunoglobulins, that may help support immune function in babies. Some studies have suggested that these components may help reduce the risk of infections and support a healthy immune system.
May be a suitable option for lactose intolerance: Some babies may have difficulty digesting lactose, which is the sugar found in milk. While goat milk still contains lactose, it may be a suitable alternative for babies who are lactose intolerant, as it contains lower levels of lactose than cow's milk.

DHA (Omega 3)
DHA (docosahexaenoic acid) is a long-chain polyunsaturated fatty acid (lipid), which belongs to the omega-3 family and supports the normal physical development of the brain and eyes.
In fact, this is an important building block of your baby’s brain and eyes, representing about 97% and 93%, respectively, of all the omega-3 fatty acids found there.
The first year of life is a critical time for your baby’s brain and eye development. Breastfed babies get DHA through their mother’s milk if she includes DHA-rich foods, such as salmon, in her diet.
Optimal levels of DHA are therefore of paramount importance for mental and visual development.
Adults can easily convert dietary fatty acids to DHA and ARA but that ability is not developed in infants, leaving breast milk as the only natural source of DHA and ARA.
To make these two important nutrients available to infants who are not breast fed, they are added to infant formula products.
The DHA in Haven is sourced from an algae called schizochytrium.
ARA (Omega 6)
ARA (arachidonic acid) is a Omega-6 polyunsaturated fatty acid (PUFA) which is naturally present in breastmilk.
ARA used in conjunction with DHA, represents a nutrient combination that is important for infant development.
Over the last decades, there has been an increased understanding of the role that ARA has in brain and cellular function.
ARA (arachidonic acid) is a major structural component of cell membranes and plays a critical role in the formation of neural tissue, particularly in the brain and retina. ARA also plays a role in the immune system, inflammation, and blood clotting.
The variety of functions related to ARA indicates its importance and in the metabolic chain of events leading to brain structural lipid development, visual development, and many other essential cellular functions.
ARA is sourced from a fungi called mortierella alpina.

Prebiotics - GOS + FOS
Prebiotics - GOS (galacto-oligosaccharides) and FOS (fructo-oligosaccharides) - are non-digestible carbohydrates that stimulate the growth and activity of beneficial bacteria in the gut.
They are important in infant formula because they help to support the development of a healthy gut microbiome, which is critical for the overall health and well-being of the infant.
A healthy gut microbiome can help to support the infant's immune system, improve nutrient absorption, and promote healthy digestion.
Prebiotics in infant formula are essential to better support the development of gut microbiome, as well as to mimic the gut ecology of the breastfed infant, who also have prebiotics from human milk.

Probiotics
Probiotics are live microorganisms that are similar to the beneficial bacteria that are naturally found in the gut. We chose to add propbiotics to Haven to help support the development of a healthy gut microbiome, which is important for the overall health and well-being of the infant. Some of the benefits of probiotics in infant formula include:
- Supporting the immune system: probiotics can help to promote the growth of beneficial bacteria in the gut, which in turn can help to support the infant's immune system.
- Improving nutrient absorption: probiotics can help to improve the absorption of certain nutrients, such as calcium and vitamin D, which are important for the growth and development of the infant.
- Promoting healthy digestion: probiotics can help to alleviate certain digestive issues, such as colic and constipation, by helping to regulate bowel movements.
- Mimicking breast milk: probiotics commonly found in breastmilk, like Lactobacillus and Bifidobacterium can be added to the formula, to mimic the gut microbiome of a breastfed infant.
Lacticaseibacillus rhamnosus HN001 is the probiotic strain added to haven. These microorganisms have been extensively researched and shown to be safe and effective for infants.

Gentle Oil Blend
Oils are added to infant formula to provide the essential fatty acids (EFAs) that are important for the growth and development of the infant. These essential fatty acids include omega-3 and omega-6 fatty acids, which are important for brain and visual development, as well as for the development and function of the immune system.
Vegetable oils such as soy, palm, corn and canola are commonly used in infant formula as a source of omega-6 fatty acids such as linoleic acid.
However, we purposely chose a healthier more gentle plant-based oil blend comprising low erucic acid canola oil, sunflower oil, high-oleic sunflower oil and coconut oil.
Coconut oil, is a source of medium chain triglycerides (MCTs) that can be easily digested and absorbed by infants.
Low erucic acid canola oil commonly referred to as LEAR oil, is a type of canola oil specifically bred to contain minimal levels of erucic acid, a naturally occurring fatty acid found in traditional rapeseed oil. Erucic acid, when consumed in high amounts, has been linked to potential health concerns, such as heart issues in animal studies, prompting the development of low-erucic varieties in the mid-20th century. This oil is derived from specially cultivated rapeseed plants (Brassica napus or Brassica rapa) and typically contains less than 2% erucic acid, compared to up to 50% in traditional rapeseed oil. In infant formula, low erucic acid canola oil serves as a valuable fat source, providing essential fatty acids like oleic acid and a balanced ratio of omega-3 and omega-6 fatty acids, which are crucial for brain development, growth, and overall health in infants. Its use ensures a safe, nutritionally appropriate alternative to breast milk fats, mimicking their composition while avoiding the risks associated with higher erucic acid content.
Sunflower oil is used as a key fat source to replicate the fatty acid profile of breast milk, providing essential nutrients vital for an infant’s growth, brain development, and energy needs. Its inclusion helps achieve a balanced blend of omega-6 fatty acids, which support cell membrane formation and neurological development, while working alongside other oils to ensure the formula meets the nutritional standards required for healthy infant development. Sunflower oil’s mild properties and low allergenic potential make it a safe and effective ingredient in these formulations.
High oleic sunflower oil is a plant-based oil that is high in monounsaturated fats, specifically oleic acid. It is also a source of linoleic acid, an essential omega-6 fatty acid. High oleic sunflower oil is easily digested by infants and can help to improve the absorption of fat-soluble vitamins such as A, D, E, and K, which are important for the growth and development of the infant.

Lutein
Lutein (pronounced loo’-teen) is a carotenoid (a group of natural pigments found in plants and vegetables) and has powerful antioxidant properties. It is found in eggs and leafy green vegetables.
The retina of the eye is an extension of the brain, and lutein protects the retina by absorbing damaging blue light. Acting as an antioxidant, lutein may also protect DHA, a key building block of the brain that is prone to damage caused by free radicals.
The concentration of lutein in the infant brain would suggest a need for lutein during brain development. In fact, recent studies on adults show a lutein-rich diet may improve visual processing, learning, memory, problem solving and verbal fluency.
Lutein is the yellow plant pigment responsible giving marigold flowers their gorgeous rich orange colour.
The lutein in Haven is extracted from marigolds and dry-blended into our formula. This will account for the very small yellow specs you might see in our powder.

Haven Nutrition Limited aims to give accurate, useful, reliable and up-to-date information on baby nutrition of the general nature and may amend the content on this site as required. To the extent permitted by law, Haven Nutrition Limited does not accept any liability or responsibility for claims, resulting from the misinterpretation of the content of this website, which is never intended to disregard, alter or discontinue professional medical advice and/or treatment. If you are ever unsure about your baby's development, concerned about the well-being of your little one or your own health, seek medical advice immediately without delay.
